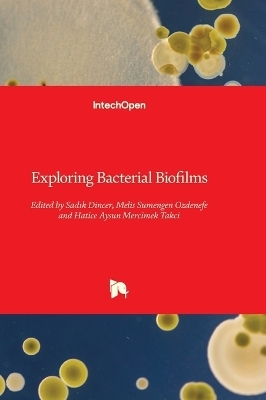
Exploring Bacterial Biofilms -

Exploring Bacterial Biofilms
Seiten
2025
IntechOpen (Verlag)
978-0-85466-947-9 (ISBN)
IntechOpen (Verlag)
978-0-85466-947-9 (ISBN)
- Titel nicht im Sortiment
- Artikel merken
| Erscheinungsdatum | 07.10.2025 |
|---|---|
| Sprache | englisch |
| Maße | 178 x 254 mm |
| Gewicht | 662 g |
| Themenwelt | Medizin / Pharmazie ► Medizinische Fachgebiete ► Mikrobiologie / Infektologie / Reisemedizin |
| ISBN-10 | 0-85466-947-7 / 0854669477 |
| ISBN-13 | 978-0-85466-947-9 / 9780854669479 |
| Zustand | Neuware |
| Informationen gemäß Produktsicherheitsverordnung (GPSR) | |
| Haben Sie eine Frage zum Produkt? |
Mehr entdecken
aus dem Bereich
aus dem Bereich
und Erste Hilfe an Bord
Buch | Softcover (2024)
MWV Medizinisch Wissenschaftliche Verlagsgesellschaft
CHF 55,90


